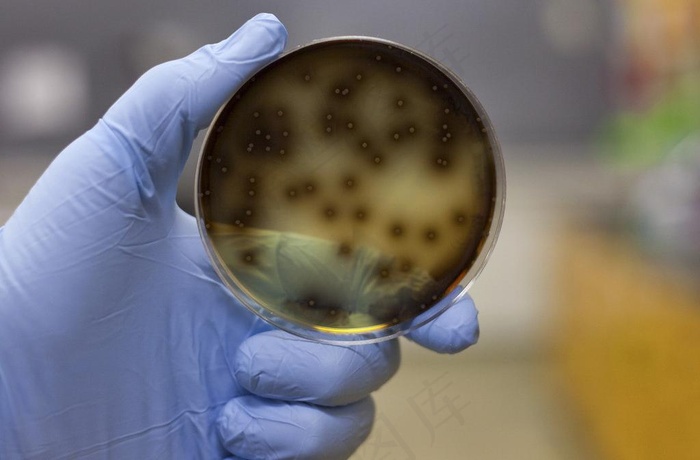
实验室图片

-
 森林公园图片
森林公园图片
-
免费
 咖啡研磨机与咖啡豆
咖啡研磨机与咖啡豆
-
 西餐红酒图片
西餐红酒图片
-
 城市建筑高楼大厦商务背景超清视频
城市建筑高楼大厦商务背景超清视频
-
 新村图片
新村图片
-
 蜈支洲岛海滩图片
蜈支洲岛海滩图片
-
 小平岛际帆船游艇港图片
小平岛际帆船游艇港图片
-
 春消息图d 花鸟画 中国古画_01...
春消息图d 花鸟画 中国古画_01...
-
 高清气球素材
高清气球素材
-
 树下学习儿童
树下学习儿童
-
免费
 卡通3d小汽车图片
卡通3d小汽车图片
-
 女性喝水图片
女性喝水图片
-
 唯美春意湖泊风车风景PSD素
唯美春意湖泊风车风景PSD素
-
 柏树双鹿中国画
柏树双鹿中国画
-
 小明吃货壁纸
小明吃货壁纸
-
 计算机科学抽象的辉光背景
计算机科学抽象的辉光背景
-
 商业创新创意图片
商业创新创意图片
-
免费
 三美神图片
三美神图片
-
 长生海蜇皇图片
长生海蜇皇图片
-
 楼盘图片
楼盘图片
-
 拿着空白广告牌的微笑商务人物图片
拿着空白广告牌的微笑商务人物图片
-
 艺术风背景
艺术风背景
-
免费
 {粉墨人生}写真样册
{粉墨人生}写真样册
-
 办公用品和笔记本
办公用品和笔记本
-
 实验室图片
实验室图片
-
 朱家尖风景图片
朱家尖风景图片
-
免费
 街景图片
街景图片
-
 毛公仔图片
毛公仔图片
-
 西北十景
西北十景
-
 茅草屋图片
茅草屋图片
-
免费
 送给爸爸的杯子图片
送给爸爸的杯子图片
-
免费
 十八阿罗汉 探手图片
十八阿罗汉 探手图片
-
 动感水花与新鲜柠檬
动感水花与新鲜柠檬
-
免费
 绿油油的草地
绿油油的草地
-
免费
 薰衣草疗法图片
薰衣草疗法图片
-
 百鲤图
百鲤图
-
免费
 蓝天白云背景素材
蓝天白云背景素材
-
 沙滩小美女图片
沙滩小美女图片
-
 满天星和玫瑰花
满天星和玫瑰花
-
 海滩图片
海滩图片